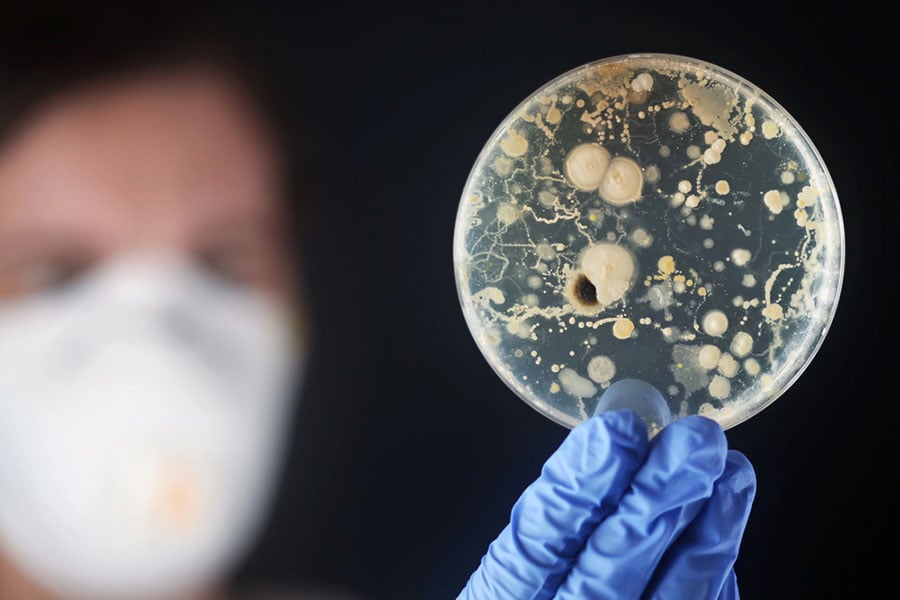
Бактерията Moraxella catarrhalis

Moraxella catarrhalis: виновницата за отит при децата

Думата “catarrhalis” идва от древногръцки – kata- (κάτω) – „надолу“ и rheo (ῥέω) – „тече“. Като медицинско понятие, „катаралис“ (catarrhalis) означава възпаление на лигавицата, което се характеризира с повишено отделяне на секрети, независимо дали причината е инфекциозна или неинфекциозна.
Бактерията Moraxella catarrhalis е човешки патоген, който обича да се настанява в горните дихателни пътища. Животните не са естествени гостоприемници, затова и лабораторни изследвания с гризачи не се увенчават с голям успех. Единственият животински вид, способен да се зарази с бактерията, е маймуната макак.
Бактерията е кръстена на Виктор Моракс – швейцарски офталмолог и бактериолог. Неговите изследвания върху очните инфекции довеждат до описанието на бактерии от този род, които предизвикват възпаления на лигавиците, включително Moraxella lacunata (свързана с конюнктивити) и Moraxella catarrhalis (честа причина за инфекции на горните дихателни пътища).
Как и кого заразява?
Moraxella catarrhalis се предава от човек на човек по въздушно-капков път – точно както много други бактерии и вируси, свързани с дихателните пътища.
Как и кого заразява Moraxella catarrhalis зависи много от възрастта на реципиента. Доста рядко възрастни хора са носители на бактерията, но пък за сметка на това повечето новородени я носят. Бактерията се настанява в горните дихателни пътища. Все още не може да се каже със сигурност какъв процент точно деца я носят. Смята се, че засяга между 28% и 100% от всички деца до 7-годишна възраст.
Тя се открива в 42% от пациентите със синузит и поне в 27% от възрастните хора с инфекция. Но носители без симптоми сред здравите възрастни е едва 1-10%. Възрастните, страдащи от белодробни заболявания (напр. муковисцидоза и хронична обструктивна белодробна болест), са по-склонни към инфекции с Moraxella catarrhalis, но те не са най-честите безсимптомни носители на бактерията.
С най-голям процент от асимптоматичните носители обикновено са групите на младите хора и децата.
Бактерията е първа причинителка на отит сред децата.
Какви болести причинява?
Инфекциите, причинени от Moraxella catarrhalis, обикновено протичат леко до умерено, особено при по принцип здрави деца и възрастни. Симптомите често наподобяват обикновена настинка (течащ нос, кашлица и лека температура) и отшумяват за няколко дни с или без лечение. При хора с отслабена имунна система, хронични белодробни заболявания или в напреднала възраст, инфекцията може да бъде по-изразена и продължителна, но рядко води до тежки усложнения. В повечето случаи не представлява сериозна опасност, но може да се наложи антибиотично лечение. при дълга продължителност.
Отит (инфекция на средното ухо)

Отитът се случва, когато течност и бактерии преминават през евстахиевата тръба, която свързва гърлото (назофаринкс) с ухото. Най-честият симптом е болка в ухото, често силна и пронизваща, като при децата може да има и повишена температура. Натрупването на течност в средното ухо може да доведе до временно намаляване на слуха. Малките деца често показват дискомфорт чрез дърпане на ухото, раздразнителност, проблеми със съня, загуба на равновесие и понякога гадене.
Пневмония
Пневмонията е инфекция на белите дробове, която често се причинява от бактерии. Въпреки че Moraxella catarrhalis обикновено не е основният причинител на пневмония, тя може да предизвика такава инфекция при възрастни хора с отслабена имунна система или хронични белодробни заболявания. Това включва състояния като хронична обструктивна белодробна болест (ХОББ), астма или фиброза, при които защитата на дихателните пътища е намалена.
Особено уязвими са пациентите, които прекарват много време в болнична среда, тъй като там рискът от заразяване с устойчиви и агресивни щамове е по-висок. При тях Moraxella catarrhalis може да доведе до по-тежко протичаща пневмония с кашлица, изразен задух, висока температура и общо неразположение.
Образните изследвания обикновено показват инфилтрат в белия дроб. В такива случаи лечението често включва специфични антибиотици и наблюдение в болнични условия.
Бронхит
Бронхитът е инфекциозно заболяване на белите дробове. Това заболяване рядко се причинява от Moraxella catarrhalis, но при възрастни с отслабена имунна система или белодробен проблем, може да се прояви и превърне в бронхит.
Общите симптоми като кашлица и секрети от гърлото и носа в продължение на седмици могат да се припокриват с пневмонията, но обикновено тя протича по-тежко, защото се засягат алвеолите и белодробния
паренхим.
Синузит
Синузитът е възпаление на синусите, което обикновено се появява след настинка или алергия, когато се наруши нормалното оттичане на секрет и се създадат условия за растеж на бактерии. Симптомите включват запушен нос, болка или тежест в областта на челото, бузите или около очите, и понякога гъст жълто-зелен секрет. Може да има и главоболие, повишена температура, умора и усещане за натиск при навеждане.
Синузитът, причинен от Moraxella catarrhalis, обикновено протича като остър бактериален синузит, по-често при деца, но може да засегне и възрастни, особено при предразполагащи фактори – алергии, хроничен ринит, анатомични аномалии, потисната имунна система.
Терапията е антибиотична. Домашните мерки не лекуват бактериалната инфекция, но могат да облекчат симптомите и да подпомогнат възстановяването.
Хронична обструктивна белодробна болест (ХОББ)

ХОББ обединява група прогресиращи белодробни заболявания като хроничен бронхит, емфизем и астма. Основните симптоми са кашлица, свирене в гърдите, задух и отделяне на гъст секрет. При пациенти с ХОББ всяка инфекция на дихателните пътища може да доведе до обостряне и влошаване на състоянието. Moraxella catarrhalis е вторият най-чест причинител на обостряне на ХОББ, тъй като увеличава количеството и гъстотата на слузта и затруднява дишането.
Лечението включва антибиотици, бронходилататори, кортикостероиди (при нужда), кислородотерапия, физиотерапия.
Конюнктивит (познат като „розово око“)
Конюнктивитът е възпаление на външната обвивка на окото и вътрешната страна на клепача. Може да бъде причинен от вируси, бактерии или алергии, като Moraxella catarrhalis е един от възможните причинители, особено при деца и новородени. Очите се зачервяват, сълзят, сърбят и понякога се отделя жълтеникав или зеленикав гноен секрет. Заболяването конюктивит е заразно и се разпространява лесно чрез контакт с ръце, кърпи или играчки.
Лечението включва локални антибактериални капки или унгвенти, както и почистване с физиологичен разтвор.
Менингит
Менингитът е сериозно състояние, при което се възпаляват менингите – защитните обвивки на мозъка и гръбначния мозък. Въпреки че повечето случаи се причиняват от други бактерии и могат да бъдат предотвратени с ваксини, Moraxella catarrhalis също може да предизвика менингит, макар и рядко. Най-често това се случва при новородени и хора с отслабен имунитет.
Менингитът, причинен от Moraxella catarrhalis, протича с висока температура, главоболие, скованост на тила, нарушено съзнание, гърчове (особено при новородени). Овладява се с антибиотична терапия в продължение на 10-14 дни.
Допълнително понякога се прилагат кортикостероиди, елекролити, притивотемпературни и други средства.
Предпазване и ваксина

Към момента науката и учените работят по разработването на ваксина срещу Moraxella catarrhalis. Това би бил много голям и успешен пробив в предотвратяването на ушни и очни инфекции сред децата. Тя би била достъпна и изключително полезна за възрастни с белодробни заболявания, които, както вече стана ясно, са податливи на инфекции от бактерията.
Но ваксината все още не е разработена и трябва да се предпазим сами от нея. Както вече споменахме, естествения щит на тялото – имунитета – понякога отслабва и бактериите се активират. За тази цел е необходимо да поддържаме имунитета си здрав и да пазим добра лична хигиена. Това може да стане лесно, ако си наложим няколко полезни навика.
- През зимата може да носим маска N95 на места с тълпи
- Мием ръцете си често и старателно: със сапун и топла вода за поне 20 секунди с усилено търкане
- Храним се с балансирана диета, богата на полезни витамини и нутриенти
- Движим се редовно
- Хидратираме се достатъчно
Разбира се, това са само няколко от важните фактори, които допринасят за здравословен начин на живот и съответно здрав имунитет.
В детските градини Moraxella catarrhalis се разпространява много лесно поради честия близък контакт между децата, споделените играчки и затворените помещения. Тъй като бактерията се предава по въздушно-капков път, едно дете, което киха, кашля или просто говори, може да разпръсне във въздуха малки капчици слюнка, съдържащи бактерията. Тези капчици могат да бъдат вдишани от други деца или да попаднат върху повърхности, до които след това се докосва друго дете. Особено при по-малките деца, които често пипат лицето си, слагат ръце или предмети в устата и не спазват добра хигиена, рискът от предаване е още по-висок.
Moraxella catarrhalis може да се намира в дихателните пътища на напълно здрави деца, които нямат никакви симптоми, но въпреки това разпространяват бактерията сред връстниците си. Това обяснява защо бактериите циркулират постоянно в такива среди, дори без наличие на видимо болни.
За да се намали рискът от инфекции, е важно децата да се учат да кихат и кашлят в сгъвката на лакътя, да си мият редовно ръцете и да избягват да споделят шишета, прибори и лични вещи. Родителите трябва да следят за първите признаци на дихателни инфекции, да не изпращат болно дете в детска градина и да уведомяват персонала при съмнение за инфекция.
В същото време редовното проветряване на помещенията, почистването на играчки и поддържането на добра обща хигиена в детската градина са ключови за ограничаване на разпространението.
Заключение
Moraxella catarrhalis е бактерия, която често присъства в дихателните пътища на децата без да причинява симптоми, но при определени условия може да доведе до различни инфекции – най-често на ушите, синусите и дихателните пътища.
Въпреки че обикновено заболяванията, които причинява, не са тежки, при хора с отслабен имунитет или хронични белодробни заболявания рискът от усложнения е по-висок. Поради лесното разпространение по въздушно-капков път, особено в затворени колективи като детските градини, е изключително важно да се поддържат високи хигиенни стандарти. До момента няма налична ваксина срещу Moraxella catarrhalis.
Блог
Рецепти
Популярни продукти
Свързани публикации
Бактериите присъстват навсякъде – включително и в нашето тяло. Някои от тях са незаменими за здравето ни, а
Това е инфекция, която може да възникне след всяко нарушение, причиняващо задържане на течност в средното ухо или
Зачервено гърло, дразнене и болка при преглъщане – всеки е изпитвал тези неприятности. Фактът, че ги познаваме, не







